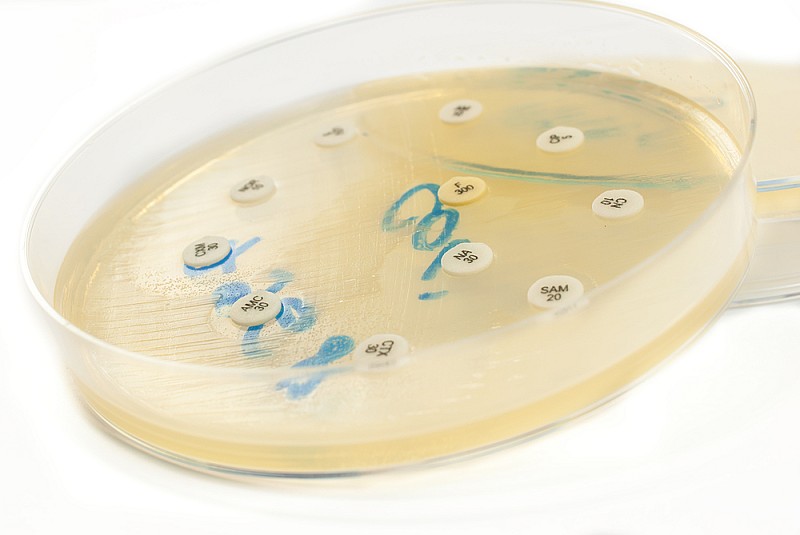
shutterstock_224019397

Antibiotico-resistenza, Iss: tassi ancora alti. Ecco dove si vedono i primi miglioramenti
Dall’Iss una fotografia della situazione riguardo igiene e antibiotico-resistenza. Ecco dieci cose da sapere per difendere noi e gli animali domestici
In Italia, le percentuali di resistenza alle principali classi di antibiotici per gli otto patogeni sotto sorveglianza continuano a mantenersi elevate, tuttavia per alcune combinazioni patogeno/antibiotico si continua ad osservare un andamento in diminuzione o sostanzialmente stabile rispetto agli anni precedenti, con l’eccezione dell’Enterococcus faecium resistente alla vancomicina, per cui l’andamento invece è in continuo preoccupante aumento. La fotografia, pubblicata in occasione della Settimana Mondiale della Consapevolezza sugli Antibiotici, viene dalle sorveglianze coordinate dall’Istituto Superiore di Sanità (ISS).
Nell’ambito del progetto INF-ACT, all’interno del Research Node 4 (EPI-MOD), l’ISS, con l’obiettivo di implementare la sorveglianza genomica dell’AMR su scala nazionale, ha rafforzato l’attività di sequenziamento dell’intero genoma (WGS) e sviluppato pipeline bioinformatiche per l’analisi genomica delle principali specie batteriche resistenti agli antibiotici, inclusi nella lista prioritaria dell’OMS, responsabili di infezioni in tutti gli ambiti di assistenza sanitaria e in comunità.
“Oggi, nel nostro Paese, l'antibiotico-resistenza causa circa 12 mila decessi ogni anno, pari a un terzo di tutti i decessi registrati tra i pazienti ricoverati in ospedale – ha affermato il presidente dell’Iss Rocco Bellantone -. Questi numeri non sono meri dati statistici: rappresentano persone, famiglie, comunità colpite da infezioni che, in buona parte, avremmo potuto evitare o curare efficacemente”.
“Non è un caso che quest’anno lo slogan scelto dall’OMS per la settimana della consapevolezza sul problema dell’antibioticoresistenza sia proprio “È ora di agire: proteggiamo il nostro presente, difendiamo il nostro futuro” – ha sottolineato il direttore generale dell’Iss Andrea Piccioli -. Abbiamo dinanzi a noi una grande sfida. Dobbiamo trasformarla in un'opportunità per costruire sistemi nazionali più robusti, interconnessi e resilienti contro le minacce sanitarie transfrontaliere”.
Anche il consumo mediano di soluzione idroalcolica nella degenza ordinaria a livello nazionale è di 9,9 litri ogni mille giornate di degenza (L/1000 GDO), valore al di sotto dello standard di riferimento stabilito dall’OMS di 20 L/1000 GDO e in calo rispetto ai 10,5 del 2023.
“Il tema della resistenza agli antibiotici va affrontato nella sua complessità– sottolinea Anna Teresa Palamara, che dirige il dipartimento di Malattie Infettive dell’Iss -. Serve uno sforzo collettivo per preservare l’efficacia degli antibiotici, che sono l’arma più preziosa che abbiamo per combattere le infezioni, e i numeri ci dicono che, anche se rimangono delle situazioni critiche da affrontare, si cominciano a vedere i primi frutti degli sforzi fatti in questo senso”.
Dieci cose da sapere sull’antimicrobico resistenza, da quante vite costa a come difendere gli animali domestici
• Ogni anno, 1,2 milioni di persone nel mondo perdono la vita a causa della resistenza agli antimicrobici. Solo in Europa, il trattamento delle infezioni causate da microbi resistenti agli antimicrobici costa quasi 12 miliardi di euro all'anno. Le infezioni resistenti comportano malattie più lunghe, meno opzioni terapeutiche e degenze ospedaliere più lunghe.
• Le infezioni da patogeni resistenti negli animali destinati alla produzione alimentare comportano trattamenti più costosi, una minore produttività e gravi implicazioni per la sicurezza alimentare. Si stima che entro il 2050 l'AMR sarà responsabile di perdite pari al fabbisogno di consumo di oltre 2 miliardi di persone all'anno. Si tratta di circa 1 persona su 5 della popolazione mondiale prevista.
• La salute umana, la salute degli animali, e la salute dell'ambiente sono intrinsecamente interconnesse e interdipendenti. L'uso massivo ed inappropriato di antimicrobici e la loro diffusione nell’ambiente ha favorito la comparsa di ceppi via via sempre più resistenti. Pertanto, contenere la resistenza agli antimicrobici richiede un approccio coordinato “One Health”.
• Gli antibiotici e altri antimicrobici devono essere assunti solo quando prescritti da un medico o da un professionista sanitario seguendo le istruzioni fornite. Interrompere un trattamento antimicrobico troppo presto può favorire comparsa e diffusione di ceppi resistenti.
• Lavarsi le mani regolarmente aiuta a prevenire le infezioni prima che si manifestino. Una buona igiene è un modo semplice ma efficace per proteggere le persone, gli animali e la salute comune.
• Usare superfici pulite, separare gli alimenti crudi da quelli cotti, cuocere bene carne, uova e frutti di mare, conservare gli alimenti deperibili in frigorifero in modo appropriato e lavare bene frutta e verdura riducono il rischio d’infezioni, con minore necessità di antimicrobici e diminuendo di conseguenza e la possibilità che si sviluppino microbi resistenti.
• Abitudini come indossare una mascherina o rimanere a casa quando si è malati aiutano a ridurre la diffusione delle infezioni sia verso altre persone, sia verso gli animali poiché alcuni microbi resistenti possono passare tra esseri umani e animali in entrambe le direzioni.
• I batteri resistenti e altri superbatteri possono infettare gli animali da compagnia, compromettendo gravemente la loro salute. Buone pratiche come controlli regolari, un rifugio pulito, una corretta igiene, una buona alimentazione e vaccinazioni aiuta a prevenire le infezioni.
• Gli antimicrobici devono essere somministrati agli animali solo su prescrizione di un veterinario secondo le istruzioni raccomandate. Gli antibiotici previsti per uso umano non devono mai essere utilizzati per uso veterinario.
• Lo smaltimento improprio degli antimicrobici danneggia l'ambiente e può contribuire alla comparsa di batteri resistenti. Portali in farmacia o segui le indicazioni locali per uno smaltimento sicuro.
nostri canali social seguendoci su:















 Eurosets presenta Landing Advance, un sistema completo e intuitivo che apre nuove frontiere nel campo del monitoraggio multiparametrico in cardiochirurgia...
Eurosets presenta Landing Advance, un sistema completo e intuitivo che apre nuove frontiere nel campo del monitoraggio multiparametrico in cardiochirurgia...






